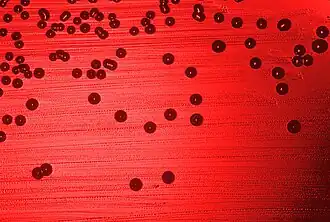

Haemophilus
| Haemophilus | ||||||||||||
|---|---|---|---|---|---|---|---|---|---|---|---|---|
Kolonien von Haemophilus influenzae in einem Blutagar | ||||||||||||
| Systematik | ||||||||||||
| ||||||||||||
| Wissenschaftlicher Name | ||||||||||||
| Haemophilus | ||||||||||||
| Winslow et al. 1917 | ||||||||||||
| Arten | ||||||||||||
Haemophilus ist eine Gattung stäbchenförmiger gramnegativer Bakterien aus der Familie der Pasteurellaceae. Die 16 Arten dieser Bakterien sind unbewegliche Stäbchen, die mitunter in den Schleimhäuten von Menschen und Tieren leben und Erkrankungen auslösen können. Beinahe alle Haemophilus-Arten sind in der Lage, ohne Sauerstoff zu überleben (fakultativ anaerob); allerdings sind sie meistens eher aerob. Der Name der Gruppe kommt von ihrer besonderen Vorliebe für Nährböden mit Blut- oder Hämoglobinzusätzen, auf denen sie in Kultur gehalten werden können.
Medizinisch bedeutsame Arten
Haemophilus influenzae
Das auch als Pfeiffer-Influenzabakterium, früher auch Influenzabazillus bzw. Bacillus influenzae, bekannte Bakterium wurde 1892 erstmals durch den Bakteriologen Pfeiffer[1] nachgewiesen, für den Erreger der „Influenza“ gehalten[2] und stellt den bekanntesten Vertreter der Haemophilus-Arten dar. Seine Popularität wurde besonders dadurch erhöht, dass es 1995 als erstes Lebewesen vollständig sequenziert wurde und somit einen Meilenstein der Genomforschung darstellt.
Das kokkoide Stäbchenbakterium wird aufgrund verschiedener Merkmale (wie eine unterschiedliche enzymatische Ausstattung) in acht Biotypen differenziert (Typ I bis VIII).[3] Es gibt Haemophilus influenzae-Stämme, die eine Kapsel bilden. Je nach Zusammensetzung der Kapsel (verschiedene Gehalte an Polysacchariden) werden diese Stämme in die Serotypen a bis f eingeteilt. Bekapselt ist H. influenzae obligat pathogen, der Typ b führt dabei am häufigsten zu invasiven Infektionen.[3] Durch die Kapsel wird eine Resistenz gegenüber Phagozytose vermittelt, wodurch dies der wichtigste Virulenzfaktor darstellt. Daneben werden IgA-Proteasen gebildet, was die lokale Immunantwort gegen H. influenzae mindert.[4]
Davon abzugrenzen ist die unbekapselte Bakterien-Variante, die einen Teil der Normalflora des Menschen darstellt. Sie macht bei Kindern etwa 1,8 %, bei Erwachsene 0,15 % der Gesamtflora aus.[4] Die unbekapselte Variante ist nur unter bestimmten Umständen, z. B. bei Epithelvorschädigung durch Giftstoffe wie Nikotin, pathogen. Eine chronische Infektion der Bronchialschleimhaut kann so etwas zum „Raucherhusten“ beitragen.[4] Da H. influenzae DNA aus der Umgebung aufnehmen kann (Kompetenz), können sowohl bekapselte Stämme ihre Kapsel verlieren als auch vice versa unbekapselte Stämme eine Kapsel bilden („Switch“).[3]
H. influenzae lebt ausschließlich in den Schleimhäuten des Menschen, als Bestandteil der Mundflora vor allem in denen des oberen Atmungssystems (Nase, Rachen bzw. Oropharynx, Luftröhre) und kann dort und in den unteren Atemwegen entzündliche Erkrankungen (Sinusitis, Epiglottitis, Bronchitis, Pneumonie, aber auch Otitis, Endokarditis und Osteomyelitis)[5] verursachen. Übertragen wird das Bakterium vor allem als Tröpfcheninfektion durch Kranke oder gesunde Keimträger, außerhalb der Schleimhäute ist es nur kurz lebensfähig. Aufgrund seiner Präsenz besonders bei Grippeerkrankungen hielt man es früher für den Erreger der Grippe, bis man das Grippevirus als tatsächlichen Verursacher identifizieren konnte. H. influenzae wird daher bei der Grippe als Erreger sekundärer Symptome angesehen, der von der Schwächung des Menschen durch die Viren profitiert. Vor allem bei (ungeimpften) Kleinkindern ist dieses Bakterium auch Erreger von Hirnhautentzündungen (Meningitis) und weiteren entzündlichen Erkrankungen. Als Prophylaxe wird eine Schutzimpfung gegen eine Haemophilus influenzae b-Infektion die HIB-Impfung empfohlen. Im Jahr 2000, vor der großflächigen Etablierung der HIB-Impfung im frühkindlichen Alter in den WHO-Mitgliedsstaaten, starben jährlich geschätzt 371.000 Kinder unter 5 Jahren an dieser impfpräventablen Infektion.[6] Die Zahl der Todesopfer in Ländern, in denen die HIB-Impfung heute standardmäßig durchgeführt wird (183 Staaten, darunter auch Deutschland) ist um bis zu 90 % gesunken.[7]
Der Nachweis erfolgt aus Sputum, Blut und Liquor per kultureller Anzucht. Idealerweise erfolgt diese auf Kochblutagar. Der Nährboden wird auch mit Bacitracin versetzt, um das Wachstum anderer Bakterien zu verhindern.[8] Alternativ schafft die oft zusätzlich verwendete „Amme“ Staphylococcus aureus bei Verwendung von Blutagar durch starke NAD+- und Hämin-Produktion ideale Wachstumsbedingungen (Ammenwachstum). Nach 1- bis 2-tägiger Inkubation bei 37 °C lassen sich glatte, leicht durchsichtige Kolonien feststellen.[4] Die Spezialdiagnose erfolgt dann biochemisch oder via MALDI-TOF, die Kapseltypisierung durch Objektträgeragglutination und via PCR.[8]
In Deutschland ist der direkte oder indirekte Nachweis von Haemophilus influenzae namentlich meldepflichtig nach § 7 des Infektionsschutzgesetzes, soweit der Nachweis auf eine akute Infektion hinweist. In der Schweiz ist der positive laboranalytische Befund zu Haemophilus influenzae meldepflichtig und zwar nach dem Epidemiengesetz (EpG) in Verbindung mit der Epidemienverordnung und Anhang 3 der Verordnung des EDI über die Meldung von Beobachtungen übertragbarer Krankheiten des Menschen.
Haemophilus ducreyi

Haemophilus ducreyi ist als Streptobacillus des Weichen Schankers (auch Ulcus molle) bekannt und ist der Erreger dieser – im Gegensatz zu Österreich – in Deutschland nicht meldepflichtigen Geschlechtskrankheit. Die Krankheit und damit auch ihr Erreger kommen vor allem in den tropischen (und armen) Regionen in Afrika, Südostasien und Lateinamerika vor. Sichtbare Symptome sind rundliche Geschwüre an den Schamlippen und im Scheidenvorhof der Frau bzw. an der Eichel und am Penisschaft des Mannes. Seit 2003 ist auch das Genom dieses Bakteriums bekannt.
Haemophilus aegyptius
Haemophilus aegyptius, auch als Koch-Weeks-Bacillus bezeichnet, ist morphologisch nicht von H. influenzae zu unterscheiden. Er ist vor allem in Nordafrika und anderen tropischen und subtropischen Kontinenten verbreitet und ist der Erreger der als purulente Konjunktivitis bekannten Augenbindehautentzündung.
Haemophilus parainfluenzae
Haemophilus parainfluenzae tritt nur sehr selten als Krankheitserreger einer Form der Endokarditis (entzündliche Veränderung der Herzinnenhaut) auf.
Haemophilus vaginalis
Hierbei handelt es sich um eine alte Bezeichnung der jetzt als Gardnerella vaginalis benannten Bakterien, die ziemlich häufig bei unspezifischen Entzündungen der Vagina und der Gebärmutter auftreten. Das Bakterium ist allerdings wahrscheinlich nicht immer pathogen, da es auch bei gesunden Frauen häufig festgestellt wird.
Haemophilus haemolyticus
Anders als die anderen Vertreter der Gattung ist Haemophilus haemolyticus in der Lage, das Hämoglobin des Blutes zu spalten und zu nutzen. Eine Rolle als Krankheitserreger ist für diese Art jedoch nicht bekannt.
Haemophilus parasuis
Erreger der Glässerschen Krankheit der Schweine. Fieberhafte Polyserositiden und Polyarthritiden dominieren das Krankheitsbild. Der Erreger wird aber auch auf den Schleimhäuten nicht erkrankter Tiere nachgewiesen. Zu ausgeprägten Krankheitsbildern kommt es meist unter Stresseinfluss. Der kulturelle Erregernachweis gelingt besonders gut aus dem Liquor cerebrospinalis unter Berücksichtigung artspezifischer Wachstumsansprüche.
Haemophilus paragallinarum
Erreger des ansteckenden Hühnerschnupfen (Coryza contagiosa). Auffälligstes klinisches Symptom ist der „Eulenkopf“, der auf Sekretstau in den Nasennebenhöhlen zurückzuführen ist.
Haemophilus haemolyticus
In der mikrobiologischen Ära vor der flächendeckenden Verbreitung von PCR und Massenspektrometrie, ist es häufiger zu Fehlinterpretationen von Untersuchungsergebnissen gekommen. H. haemolyticus ist in dieser Zeit beispielsweise als nicht weiter typisierbarer H. influenzae fehlbestimmt worden. Einerseits weil Untersuchungsergebnisse H. influenzae nicht ausschlossen, andererseits weil beide Erreger den gleichen Lebensraum besiedeln.[9] Auch H. haemolyticus kann invasive Erkrankungen, ähnlich denen von H. influenzae auslösen. Nachweise sind jedoch seltener.
Ehemalige Vertreter
Haemophilus somnus galt taxonomisch für die Einteilung in die Gattung Haemophilus als fragwürdig. Nach Bergey’s Manual gehört er zu den species incertae sedis. Die Unabhängigkeit sowohl vom X- als auch vom V-Faktor widerspricht allerdings der Einordnung in die Gattung Haemophilus. Die als Haemophilus agni und Histophilus ovis beschriebenen Bakterien wurden deshalb mit H. somnus in der neuen Art Histophilus somni zusammengefasst. Er ist der Erreger der ISTME (Infektiöse, septikämische, thrombosierende Meningoencephalitis) des Rindes. Symptome sind fieberhafte Allgemeinerkrankungen mit zentralnervösen Erscheinungen. Des Weiteren kann der Erreger an Endometriden, Mastitiden, Aborten und der Geburt lebensschwacher Kälber beteiligt sein.
Therapie
Therapie der Wahl sind die Antibiotika Amoxicillin (gegebenenfalls zusammen mit einem Beta-Lactamase-Inhibitoren wie Clavulansäure, z. B. als Kombi-Präparat) oder Moxifloxacin.
Weitere gegen Haemophilus (influenzae) einsetzbare Antibiotika sind Ampicillin, Cefuroxim(-Axetil), Cefotiam, Cefpodoxim-Proxetil, Cefotaxim, Doxycyclin, Ceftriaxon, Meropenem (insbesondere bei Meningitis), Ciprofloxacin und Levofloxacin. Bei schweren Infektionen eignen sich vor allem Ceftriaxon, Cefotaxim, Chinolone, Ertapenem, Imipenem, Levofloxacin und Meropenem. Gegen Cephalosporine der 1. Generation ist Hämophilus primär resistent.[10]
Literatur
- Stichwörter „Haemophilus“, „Haemophilus“, „Haemophilus aegypticus“, „Haemophilus ducreyi“, „Haemophilus haemolyticus“, „Haemophilus influenzae“, „Haemophilus parainfluenzae“, „Haemophilus vaginalis“. In: Pschyrembel Medizinisches Wörterbuch. 257. Auflage, Walter de Gruyter, Berlin 1993; S. 588
- Michael Rolle, Anton Mayr: Medizinische Mikrobiologie, Infektions- und Seuchenlehre. 8. Auflage, MVS Medizinverlage Stuttgart 2006, ISBN 978-3-8304-1060-7.
- Joanna E. L'Heureux, Anne Corbett, Clive Ballard, David Vauzour, Byron Creese, Paul G. Winyard, Andrew M. Jones, Anni Vanhatalo: Oral microbiome and nitric oxide biomarkers in older people with mild cognitive impairment and APOE4 genotype. In: PNAS Nexus, Band 4, Nr. 1, 28. Januar 2025, S. pgae543; doi:10.1093/pnasnexus/pgae543 (englisch).
Weblinks
- Haemophilus influenzae – Informationen des Robert Koch-Instituts
Einzelnachweise
- ↑ Manfred Vasold: Influenzabazillus (Haemophilus influenzae). In: Werner E. Gerabek, Bernhard D. Haage, Gundolf Keil, Wolfgang Wegner (Hrsg.): Enzyklopädie Medizingeschichte. De Gruyter, Berlin / New York 2005, ISBN 3-11-015714-4, S. 671.
- ↑ Richard Pfeiffer: Die Aetiologie der Influenza. In: Zeitschrift für Hygiene und Infektionskrankheiten. Band 13, 1893, S. 357–386.
- ↑ a b c Ulrich Heininger: Haemophilus influenzae Typ b. In: Heinz Spiess, Ulrich Heininger, Wolfgang Jilg (Hrsg.): Impfkompendium. 8. Auflage. Georg Thieme Verlag, 2015, ISBN 978-3-13-498908-3, S. 173 f., doi:10.1055/b-0035-127583.
- ↑ a b c d Herbert Hof, Rüdiger Dörries: Medizinische Mikrobiologie. 5. Auflage. Thieme, Stuttgart 2014, ISBN 978-3-13-152965-7, S. 426–428.
- ↑ Marianne Abele-Horn (2009), S. 264.
- ↑ Watt et al.: Burden of disease caused by Haemophilus influenzae type b in children younger than 5 years: global estimates. In: The Lancet, Volume 374, Issue 9693, S. 903–911. doi:10.1016/S0140-6736(09)61203-4
- ↑ Haemophilus influenzae Typ b (Hib) » Kinderaerzte-im-Netz. Abgerufen am 1. März 2019.
- ↑ a b Thiên-Trí Lâm und Ulrich Vogel: Haemophilus. In: Sebastian Suerbaum, Gerd-Dieter Burchard, Stefan H. E. Kaufmann, Thomas F. Schulz (Hrsg.): Medizinische Mikrobiologie und Infektiologie. Springer-Verlag, 2016, ISBN 978-3-662-48678-8, S. 285, doi:10.1007/978-3-662-48678-8_33.
- ↑ Raydel Anderson, Xin Wang, Elizabeth C. Briere, Lee S. Katz, Amanda C. Cohn, Thomas A. Clark, Nancy E. Messonnier, Leonard W. Mayer: Haemophilus haemolyticus Isolates Causing Clinical Disease. In: Journal of Clinical Microbiology. Band 50, Nr. 7, Juli 2012, ISSN 0095-1137, S. 2462–2465, doi:10.1128/JCM.06575-11, PMID 22573587, PMC 3405640 (freier Volltext).
- ↑ Marianne Abele-Horn: Antimikrobielle Therapie. Entscheidungshilfen zur Behandlung und Prophylaxe von Infektionskrankheiten. Unter Mitarbeit von Werner Heinz, Hartwig Klinker, Johann Schurz und August Stich, 2., überarbeitete und erweiterte Auflage. Peter Wiehl, Marburg 2009, ISBN 978-3-927219-14-4, S. 194 und 264.